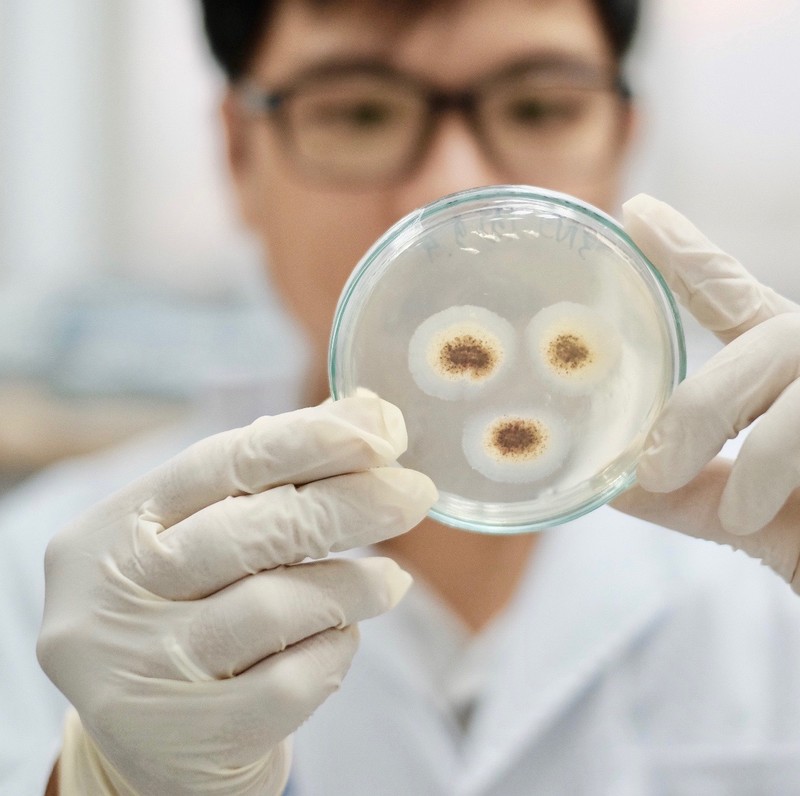
Để nền công nghiệp sinh học Việt Nam vươn tầm: Tiếp thị để chuyển giao khoa học công nghệ ảnh 3

Mới đây, Bộ NN-PTNT tổ chức cuộc họp Ban Điều hành Đề án phát triển công nghiệp sinh học ngành nông nghiệp đến năm 2030 và cuộc họp triển khai Chiến lược phát triển KHCN và đổi mới sáng tạo ngành nông nghiệp đến năm 2030, tầm nhìn đến năm 2050. Tại cuộc họp, Thứ trưởng Bộ NN-PTNT Phùng Đức Tiến đã có những chia sẻ về thực trạng đầu tư, phát triển công nghệ sinh học những năm qua, cũng như những định hướng phát triển nền công nghiệp sinh học trong thời gian tới. Báo SGGP xin trích lược ý kiến của Thứ trưởng Phùng Đức Tiến.
Phát triển KHCN và đổi mới sáng tạo trở thành động lực quan trọng
Để thúc đẩy nông nghiệp Việt Nam phát triển nhanh và bền vững, ngày 24-3-2021, Thủ tướng Chính phủ đã ban hành Quyết định số 429 phê duyệt Đề án Phát triển công nghiệp sinh học trong ngành nông nghiệp đến năm 2030. Đề án đặt ra mục tiêu phát triển ngành công nghiệp sinh học có giá trị gia tăng cao, bền vững, thân thiện với môi trường, nâng cao tiềm lực nghiên cứu phát triển, ứng dụng và làm chủ công nghệ sinh học hiện đại của khu vực và thế giới, đưa Việt Nam trở thành quốc gia có trình độ công nghệ sinh học ngang bằng các nước tiên tiến trong khu vực trên thế giới.
![]() |
| Thứ trưởng Bộ NN-PTNT Phùng Đức Tiến. Ảnh: VĂN PHÚC |
Đáng chú ý, đầu năm 2023, Bộ Chính trị đã ban hành Nghị quyết số 36 về phát triển và ứng dụng công nghệ sinh học phục vụ phát triển bền vững đất nước trong tình hình mới, nội dung bao quát toàn diện trên nhiều lĩnh vực, không chỉ riêng nông nghiệp. Theo Nghị quyết số 36, đến năm 2045 Việt Nam sẽ là quốc gia có nền công nghiệp sinh học phát triển trên thế giới, công nghiệp sinh học đóng góp 10-15% vào GDP…
Cũng liên quan mục tiêu phát triển KHCN trong lĩnh vực nông nghiệp, ngày 16-1-2023, Bộ trưởng Bộ NN-PTNT đã ký Quyết định số 296 phê duyệt “Chiến lược phát triển KHCN và đổi mới sáng tạo ngành nông nghiệp đến năm 2030, tầm nhìn đến năm 2050”. Mục tiêu tổng quát của Chiến lược là phát triển KHCN và đổi mới sáng tạo trở thành động lực quan trọng để xây dựng nền nông nghiệp có năng suất, chất lượng, hiệu quả và khả năng cạnh tranh cao, bền vững, thuộc nhóm dẫn đầu trong khu vực và quốc tế, gắn với xây dựng nông thôn mới hiện đại. Xây dựng hệ thống các tổ chức KHCN ngành nông nghiệp đủ tiềm lực và trình độ tạo ra các luận cứ và sản phẩm khoa học có giá trị cao, tiếp thu chọn lọc và làm chủ các công nghệ tiên tiến của thế giới, chuyển giao ứng dụng, nhân rộng trong thực tiễn sản xuất; góp phần nâng cao thu nhập và cải thiện đời sống của nông dân, bảo vệ môi trường, ứng phó với biến đổi khí hậu và giảm phát thải khí nhà kính.
![]() |
| Thử nghiệm các loại vaccine, tế bào có khả năng kháng dịch bệnh trên chuột bạch tại Phòng Thí nghiệm trọng điểm CNSH thú y (Học viện Nông nghiệp Việt Nam). Ảnh: VIẾT CHUNG |
Mục tiêu cụ thể của chiến lược là: Đến năm 2030 có ít nhất 60% kết quả nghiên cứu được công nhận tiến bộ kỹ thuật và áp dụng vào sản xuất, trong đó khoảng 15% kết quả nghiên cứu được đăng ký bản quyền sáng tạo, sở hữu trí tuệ. Tổng giá trị chuyển giao công nghệ, thương mại hóa kết quả nghiên cứu từ các viện nghiên cứu, trường đại học thuộc Bộ NN-PTNT cho doanh nghiệp tăng 20% trong giai đoạn 2021-2025 và 35% trong giai đoạn 2026-2030.
Lãnh đạo viện trường cũng phải như tổng giám đốc
Chúng ta cần nhận thức một cách nghiêm túc rằng KHCN là quốc sách hàng đầu và tái cơ cấu nông nghiệp, đổi mới sáng tạo là động lực. Trong bối cảnh quốc tế thay đổi đến chóng mặt, các quốc gia bây giờ cạnh tranh nhau chủ yếu là bằng KHCN thì Việt Nam không thể đứng ngoài cuộc hoặc tụt lại phía sau. Đó là lý do chúng ta cần phải chuẩn bị một chiến lược KHCN để phục vụ chiến lược phát triển công nghiệp và chiến lược nội ngành nông nghiệp như: trồng trọt – chăn nuôi – thủy sản. Mục tiêu mà chiến lược đề ra là rất đúng và cần thiết.
![]() |
| Từ hoạt động nghiên cứu, các nhà khoa học của Trung tâm Công nghệ sinh học TPHCM cho ra đời nhiều sản phẩm có tính ứng dụng cao. Ảnh: ĐĂNG QUÂN |
Để tổ chức thực hiện các nội dung cũng như mục tiêu mà chiến lược đề ra, tôi cho rằng:
Thứ nhất là về cơ chế chính sách, cần rà soát lại cái gì hợp lý, cái gì còn chưa hợp lý để tháo gỡ ngay. Bộ NN-PTNT sẽ đi đến tận cùng để tháo gỡ khó khăn, bất cập.
Thứ hai là chúng ta sẽ xem lại đội ngũ các nhà khoa học, nguồn nhân lực. Hiện nay, nguồn nhân lực chất lượng cao để phục vụ cho công nghiệp sinh học trong nông nghiệp rất quan trọng nhưng thiếu cả số lượng lẫn chất lượng. Những năm qua, số lượng chuyên gia hao hụt, mai một dần. Cho nên, để đánh giá đúng thực lực của mình, cần phải thống kê xem 10 năm qua đào tạo được bao nhiêu giáo sư, tiến sĩ, thạc sĩ… và số nhân lực rời đi là bao nhiêu?
Thứ ba là về cơ sở dữ liệu KHCN và cơ sở vật chất, cũng phải rà soát, đánh giá mức độ hiệu quả đầu tư, tránh lãng phí.
Thứ tư là về nguồn kinh phí cho KHCN, hiện có rất nhiều đầu mối, nhưng các đơn vị nghiên cứu phải xác định nguồn kinh phí của mình ở khu vực nào. Chúng ta cũng cần học hỏi cách làm của Tổ chức Jica (Nhật Bản), họ tự nghiên cứu triển khai, tiếp cận thị trường bằng sự tự chủ. Hiện nay chúng ta thực hiện cơ chế tự chủ, lãnh đạo viện trường cũng phải như tổng giám đốc, phải tiếp thị để chuyển giao KHCN.
Thứ năm là đẩy mạnh hợp tác quốc tế. Đây là giải pháp quan trọng với công nghiệp sinh học, khi chúng ta có thể vừa đào tạo đội ngũ nhân lực chất lượng cao, vừa có thể tận dụng, học hỏi công nghệ của các doanh nghiệp nước ngoài. Hợp tác quốc tế gắn với đào tạo phải có chọn lọc, phải tìm những nhà khoa học tâm huyết với ngành. Để chuyển giao KHCN, theo tôi cần phải đẩy mạnh hợp tác quốc tế, đồng thời đẩy mạnh hợp tác chặt chẽ giữa cơ quan nghiên cứu và doanh nghiệp vì doanh nghiệp mới có tiềm lực mạnh.
Cuối cùng là nghiên cứu KHCN phải ra sản phẩm. Bộ NN-PTNT đã đặt đầu bài cho các nhà khoa học và các nhà khoa học phải biết sẽ cho ra sản phẩm gì và tính hiệu quả trong ứng dụng thực tiễn thế nào, không nghiệm thu xong cất ngăn kéo. Các nhà khoa học cũng cần đổi mới sáng tạo trong các đề tài nghiên cứu, không loanh quanh với các đề tài cũ.
![]() |
| Dây chuyền đóng gói chế phẩm serum từ dịch chiết tế bào gốc nhung hưu tại Công ty TNHH Mediworld. Ảnh: ĐĂNG QUÂN |
“Hiện nay, nguồn tài chính cho KH-CN không thiếu nhưng nằm ở những đầu mối khác nhau như các chương trình quốc gia, nguồn từ địa phương, nguồn từ các doanh nghiệp, trong khi ở Bộ NN-PTNT chỉ một phần nhỏ, nhưng việc khai thác nguồn lực bên ngoài thì còn rất yếu. Vai trò của các cơ quan nội tại trong bộ, các cục, trung tâm, các viện, các trường và khối các nhà khoa học là vô cùng quan trọng. Nếu chúng ta không đổi mới tư duy thì việc huy động nguồn lực bên ngoài sẽ gặp rất nhiều khó khăn”
Bà NGUYỄN THỊ THANH THỦY, Vụ trưởng Vụ KH-CN và Môi trường (Bộ NN-PTNT)
Trong quá trình hoàn thiện khung pháp lý về công nghệ sinh học, cần tính toán bổ sung các cơ chế chính sách mới để huy động nguồn vốn đầu tư đủ mạnh vào lĩnh vực CNSH; đặc biệt phải có chính sách ưu đãi hơn nữa trong việc thu hút các doanh nghiệp, nhà đầu tư nước ngoài mới có thể xây dựng được một ngành CNSH vững mạnh và có sự đột phá. Những lĩnh vực thế mạnh của Việt Nam cần nguồn lực đầu tư là: nông nghiệp, thủy sản, dược liệu, vaccine và chăm sóc bảo vệ sức khỏe. Với sự phát triển mạnh mẽ nền CNSH của thế giới thì các quy chuẩn về sản phẩm CNSH ở Việt Nam như giống cây trồng, vật nuôi, sản phẩm biến đổi gen, tế bào… cần phải được sửa đổi để không lạc hậu so với thế giới.
QUỐC KHÁNH
TS NGUYỄN NGÔ QUANG, Phó Cục trưởng Cục Khoa học công nghệ và đào tạo, Chánh văn phòng Hội đồng Đạo đức quốc gia, Bộ Y tế:
Hành lang pháp lý đủ mạnh để bảo vệ sản phẩm cuối
Y tế là lĩnh vực rất nhạy cảm, liên quan trực tiếp tới sức khoẻ con người nên để phát triển CNSH trong y học rất cần sự ủng hộ của Chính phủ, Quốc hội và các bộ, ngành chức năng trong việc xây dựng các quy định pháp luật, hành lang pháp lý đủ mạnh. Bởi việc nghiên cứu và ứng dụng CNSH trong y tế là một quá trình rất dài từ khi có ý tưởng, tới quá trình nghiên cứu, thử nghiệm và tạo ra sản phẩm đưa vào ứng dụng trong thực tế; và sản phẩm cuối cùng khi ra đời không phải lúc nào cũng thành công, mà còn có cả rủi ro. Cùng với đó cần quan tâm đầu tư, đẩy mạnh công tác đào tạo nguồn nhân lực và tích hợp có hệ thống giữa cơ quan quản lý, nhà nghiên cứu và sản xuất, ứng dụng để có thể tạo ra những sản phẩm có giá trị thực tiễn và được pháp luật bảo vệ.
MINH KHANG
PGS-TS DƯƠNG VĂN CHÍN, nguyên Phó Viện trưởng Viện lúa ĐBSCL:
Bảo vệ tác quyền, hỗ trợ chuyển quyền sản xuất
Để việc nghiên cứu và ứng dụng sản phẩm CNSH cho cây lúa (giống lúa mới, chế phẩm vi sinh các loại) tại ĐBSCL, chúng ta cần theo dõi, tổng kết những thành quả hiện có tại các viện trường (kể cả của cá nhân), ủng hộ họ đăng ký tác quyền, dùng luật pháp bảo vệ tác quyền của những nghiên cứu tạo ra sản phẩm. Hỗ trợ những công ty khởi nghiệp nhận chuyển quyền sản xuất và kinh doanh các sản phẩm để phục vụ sản xuất đại trà. Đối với các sản phẩm nhập khẩu: Ủng hộ một phần chi phí để các viện trường trong nước khảo nghiệm các sản phẩm CNSH tiên tiến, kết luận sớm các sản phẩm có thể sử dụng tại Việt Nam. Đối với các doanh nghiệp sử dụng, kinh doanh các sản phẩm CNSH nhập khẩu thì miễn thuế nhập khẩu các sản phẩm này cho họ trong những giai đoạn đầu (5-10 năm)…
VĨNH TƯỜNG

English